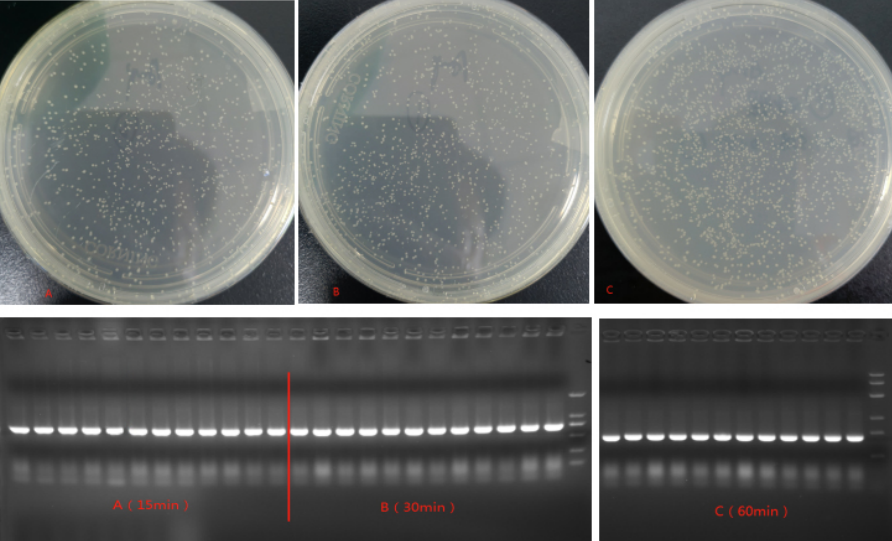
新闻图片3

武汉华美生物工程有限公司CUSABIO®品牌商
15 年
手机商铺
商家活跃:
产品热度:
- NaN
- 0
- 0
- 2
- 2
Exosome Isolation Kit外泌体提取试剂盒
¥2000 - 6000
推荐产品
公司新闻/正文
无缝克隆试剂盒,让载体构建更轻松!
906 人阅读发布时间:2023-07-28 13:40
提起“载体构建”,大家可能想到的是酶切酶连法,即使用限制性内切酶切割产生黏性末端,再使用T4 DNA 连接酶连接片段。该方法连接时间长、操作繁琐、阳性率低。相信每个做过分子实验的人可能都会有这样的经历:经过多次的 PCR、酶切、连接、转化之后,阳性率依旧很低,到底是哪一步出了问题???前前后后做几天还没几个阳性克隆,一不小心从头开始。。。
今天就给大家详解可以一步法快速构建同源重组载体,并且阳性率很高的方式:无缝克隆。
无缝克隆技术是一种新的、快速、简洁的克隆方法,可以在质粒的任何位点进行一个或多个目标 DNA 的片断的插入,而不需要任何限制性内切酶。突破传统的双酶切再加上连接,只需要一步重组法,即可得到高效率克隆的重组载体,大大提高了工作效率。
无缝克隆原理
 操作步骤
操作步骤
无缝克隆实验的主要操作可以分为3个步骤:
1. 获取线性化载体
①酶切法:在目的载体上选取合适的酶切位点进行单酶切或双酶切,对酶切后的质粒进行胶回收纯化;
②反向PCR法:在插入位点的两侧设计一对方向相反的引物对目的载体进行扩增,通过胶回收获取线性化的质粒片段。
2. 通过PCR获取插入片段
在引物5’端引入同源序列,使扩增产物与线性化载体之间具有完全一致的序列(15-25 bp)。
3. 无缝克隆反应
将线性化载体、插入片段以及无缝克隆反应液按比例混合,恒温反应5-60 min。
通过以上三步,就可以完成质粒重组。只要再进行后续的转化感受态、菌落PCR等操作,就可以获得阳性克隆。
无缝克隆试剂盒产品特点
位点选择灵活:载体任意位置基因克隆;
快速简便:一小时内可以完成载体构建;
克隆效率高,阳性克隆高达90%以上;
一次进行多片段目的基因的重组。
实验结果


订购信息

华美·科赛格不仅可以为客户提供相关分子生物学产品,并且能够根据客户需求依托公司深厚的技术积累和研发创新实力,为客户提供个性化定制开发和针对性的系统解决方案,以客户为中心,全力满足客户需求。
华美·科赛格提供优质的单克隆抗体、多克隆抗体、诊断蛋白、生化酶、分子生物学产品以及通用原料,同时可以为客户提供oem试剂及专业的定制化服务。产品全面覆盖炎症标志物、心肌标志物、肿瘤标志物、肝功肾功、甲功激素、自身免疫疾病、呼吸道病原体、动物传染病等领域;广泛应用于免疫比浊、免疫层析、酶联免疫、化学发光、临床生化和分子诊断等平台。可为广大体外诊断试剂厂商提供一定量的免费试用装,赶紧联系我们哦!
需要了解更多信息,请与我们联系:
QQ:3149924161
邮箱:market@cusag.cn
网站:www.cusag.cn
我们将一如既往地为您提供高品质抗体、抗原原料和更好的服务,助力诊断,我们一直都在!
今天就给大家详解可以一步法快速构建同源重组载体,并且阳性率很高的方式:无缝克隆。
无缝克隆技术是一种新的、快速、简洁的克隆方法,可以在质粒的任何位点进行一个或多个目标 DNA 的片断的插入,而不需要任何限制性内切酶。突破传统的双酶切再加上连接,只需要一步重组法,即可得到高效率克隆的重组载体,大大提高了工作效率。
无缝克隆原理

无缝克隆实验的主要操作可以分为3个步骤:
1. 获取线性化载体
①酶切法:在目的载体上选取合适的酶切位点进行单酶切或双酶切,对酶切后的质粒进行胶回收纯化;
②反向PCR法:在插入位点的两侧设计一对方向相反的引物对目的载体进行扩增,通过胶回收获取线性化的质粒片段。
2. 通过PCR获取插入片段
在引物5’端引入同源序列,使扩增产物与线性化载体之间具有完全一致的序列(15-25 bp)。
3. 无缝克隆反应
将线性化载体、插入片段以及无缝克隆反应液按比例混合,恒温反应5-60 min。
通过以上三步,就可以完成质粒重组。只要再进行后续的转化感受态、菌落PCR等操作,就可以获得阳性克隆。
无缝克隆试剂盒产品特点
位点选择灵活:载体任意位置基因克隆;
快速简便:一小时内可以完成载体构建;
克隆效率高,阳性克隆高达90%以上;
一次进行多片段目的基因的重组。
实验结果

图1.无缝克隆试剂盒克隆不同长度的的单片段基因
图2.无缝克隆试剂盒不同孵育时间,克隆效果相同
订购信息

华美·科赛格不仅可以为客户提供相关分子生物学产品,并且能够根据客户需求依托公司深厚的技术积累和研发创新实力,为客户提供个性化定制开发和针对性的系统解决方案,以客户为中心,全力满足客户需求。
华美·科赛格提供优质的单克隆抗体、多克隆抗体、诊断蛋白、生化酶、分子生物学产品以及通用原料,同时可以为客户提供oem试剂及专业的定制化服务。产品全面覆盖炎症标志物、心肌标志物、肿瘤标志物、肝功肾功、甲功激素、自身免疫疾病、呼吸道病原体、动物传染病等领域;广泛应用于免疫比浊、免疫层析、酶联免疫、化学发光、临床生化和分子诊断等平台。可为广大体外诊断试剂厂商提供一定量的免费试用装,赶紧联系我们哦!
需要了解更多信息,请与我们联系:
QQ:3149924161
邮箱:market@cusag.cn
网站:www.cusag.cn
我们将一如既往地为您提供高品质抗体、抗原原料和更好的服务,助力诊断,我们一直都在!



